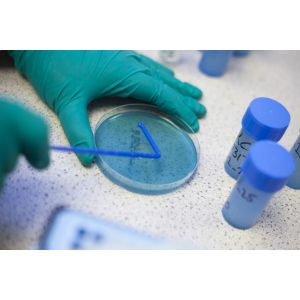

DISCOVER THE SECRET
Murphy Science
Lab Services
Murphy Hub
Unlock the world of Murphy's
Murphy Hub
Unlock the world of Murphy's
Say hello to
Everything you need in one place.
We have created a world of secrets for beverage makers. So you can explore, watch, learn, and discover new ways to improve your craft with confidence. Welcome to the Murphy Hub.


Tech Support
Sign up to get free support


Training & Events
Learn from our experts


Lab Analysis
Browse our UKAS tests


Product Innovation
Find your secret ingredient
Murphy & Son
Professional support. Wherever you are.
New in at Murphy's.
Check out the latest products here.




New in at Murphy's.


Low Alcohol Yeast
A specially selected maltose-negative yeast strain designed to produce clean, flavourful low alcohol beers with minimal off-flavours, ideal for a wide range of beers.


Alpha
A heat-stable alpha-amylase enzyme, derived from Baciluslicheniformis which breaks down starch into shorter dextrins and fermentable sugars at high temperatures.


BetaBreak
Our new ezyme designed to improve beer clarity. BetaBreak reduces wort viscosity, improves mash separation and lautering efficiency, and helps prevent stuck mashes.
Learn from our experts.
At Murphy & Son, our team of experts ensure we remain industry leaders in the provision of specialised technical guidance for brewers, winemakers & distillers.
Unlock pioneering research to discover news ways of mastering your craft.
Posts
Something for our brewers.
Explore, watch, learn, and discover new ways to improve your craft with confidence.
Lights, camera, ABEN.
Discover this Brewer's Secret.
Lab Analysis
To ensure the highest quality in every batch, our state-of-the-art Chemistry and Microbiological Analysis Service provides an essential tool for brewers, winemakers & distillers aiming to achieve perfection in their craft.
State of the art facilities
Led by science.
Get technical
Driven by technology.
Say hello to
Everything you need in one place.
We have created a world of secrets for beverage makers. So you can explore, watch, learn, and discover new ways to improve your craft with confidence. Welcome to the Murphy Hub.
Frances Maud, Technical Sales Manager
discover
Discover our TechHub
learn
Read. Learn. Share.
Brewing with Murphys.
The number one supplier for the brewing industry since 1887.
I am a text block, this is where you can explain the brewers secret. What the company does for brewers, why our products are the key to brewing brilliant beer. A unique combination of lab support, tech support and master brewers.A history unmatched when it comes to decided where you buy your secret ingredients from.
I am a text block, this is where you can explain the brewers secret. What the company does for brewers, why our products are the key to brewing brilliant beer. A unique combination of lab support, tech support and master brewers.A history unmatched when it comes to decided where you buy your secret ingredients from.
Brewing with Murphys.
The number one supplier for the brewing industry since 1887.
Read our blogs
Learn from our experts and unlock the keys to the Brewers Secret.
foam
Shop Now
Finings
Shop Now
Malt
Shop Now
Yeast
Shop Now
Enzymes
Shop Now
dehaze
Shop Now
finings
Shop Now
super f
Shop Now
koppakleer
Shop Now
protafloc
Shop Now
zinc sulphate
Shop Now
dehaze
Shop Now
malt
Shop Now
super f
Shop Now
koppakleer
Shop Now
protafloc
Shop Now
zinc sulphate
Shop Now
dehaze
Shop Now
yeast
Shop Now
plzen
Shop Now
chico maestro
Shop Now
blanc canvas
Shop Now
sour trapp
Shop Now
dried
Shop Now
hygiene
Shop Now
plzen
Shop Now
chico maestro
Shop Now
blanc canvas
Shop Now
sour trapp
Shop Now
dried
Shop Now
enzymes
Shop Now
plzen
Shop Now
chico maestro
Shop Now
blanc canvas
Shop Now
sour trapp
Shop Now
dried
Shop Now
liquor treatments
Shop Now
plzen
Shop Now
chico maestro
Shop Now
blanc canvas
Shop Now
sour trapp
Shop Now
dried
Shop Now
preservatives & stabilisers
Shop Now
plzen
Shop Now
chico maestro
Shop Now
blanc canvas
Shop Now
sour trapp
Shop Now
dried
Shop Now
foam
Shop Now
Finings
Shop Now
Malt
Shop Now
Yeast
Shop Now
Enzymes
Shop Now
dehaze
Shop Now
More from Murphy's
Made better with Murphys. Suppling the drinks industry since 1887.


Murphy & Son, Alpine Street, Old Basford, Nottingham, NG6 0HQ, United Kingdom.
Murphy & Son Ltd | 0115 978 5494 | Legal Pages